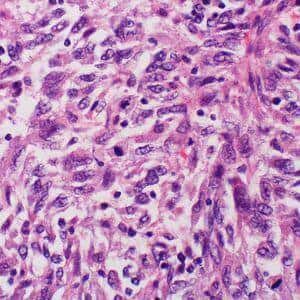

Two articles in The New England Journal of Medicine regarding a new class of anticancer drugs show substantial benefit.
Nivolumab [pronounced nye vol’ ue mab] is a monoclonal antibody that blocks a protein called programmed cell death or PD-1. The brand name is OPDIVO.
Hodgkin’s Lymphoma
In one study, patients with Hodgkin’s lymphoma who had relapsed or were resistant to existing treatments were given nivolumab. The infestigators reported a substantial therapeutic effect with 17% of patients demonstrating a complete response and 70% experiencing a partial response.
Metastatic Melanoma
The other article reported patients with metastatic melanoma also benefit from nivolumab. Patients who had not been previously treated survived longer if they got nivolumab rather than a standard melanoma chemotherapy, dacarbazine. At one year, 72 percent of the nivolumab-treated patients were still alive, compared to 42 percent of those who had received dacarbazine.
An editorial accompanying this research was titled “Release the Hounds! Activating the T-Cell Response to Cancer.” Immunotherapy for cancer is finally coming of age.
photo credit: Yale Rosen https://www.flickr.com/photos/pulmonary_pathology/ cc license cropped